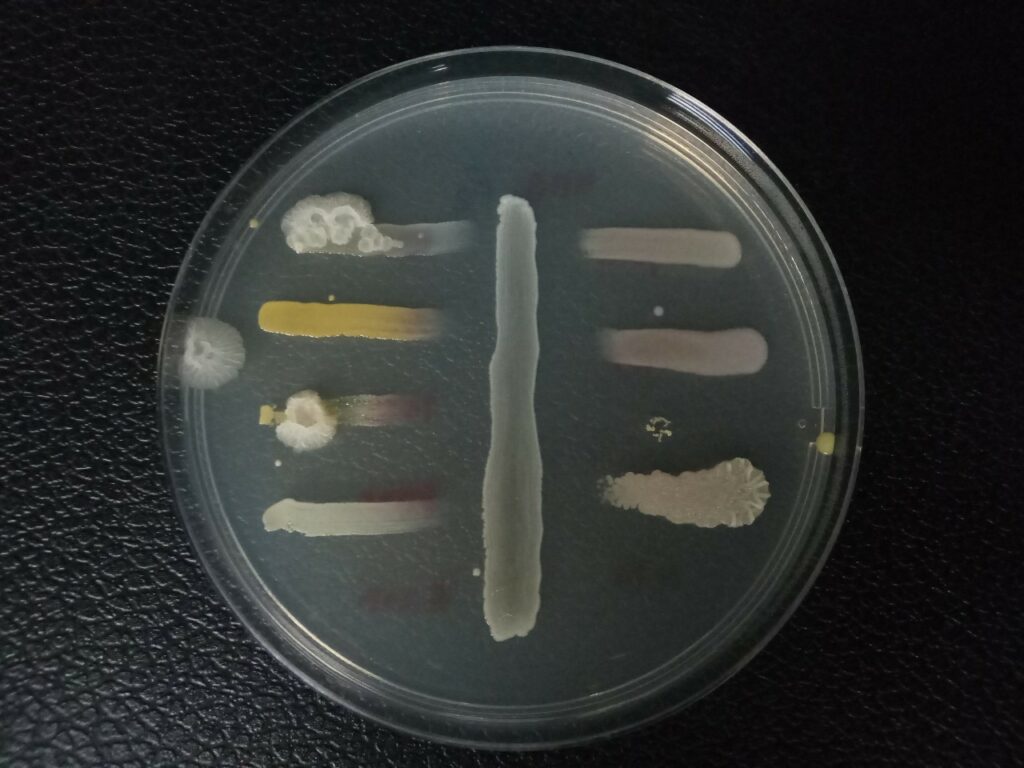
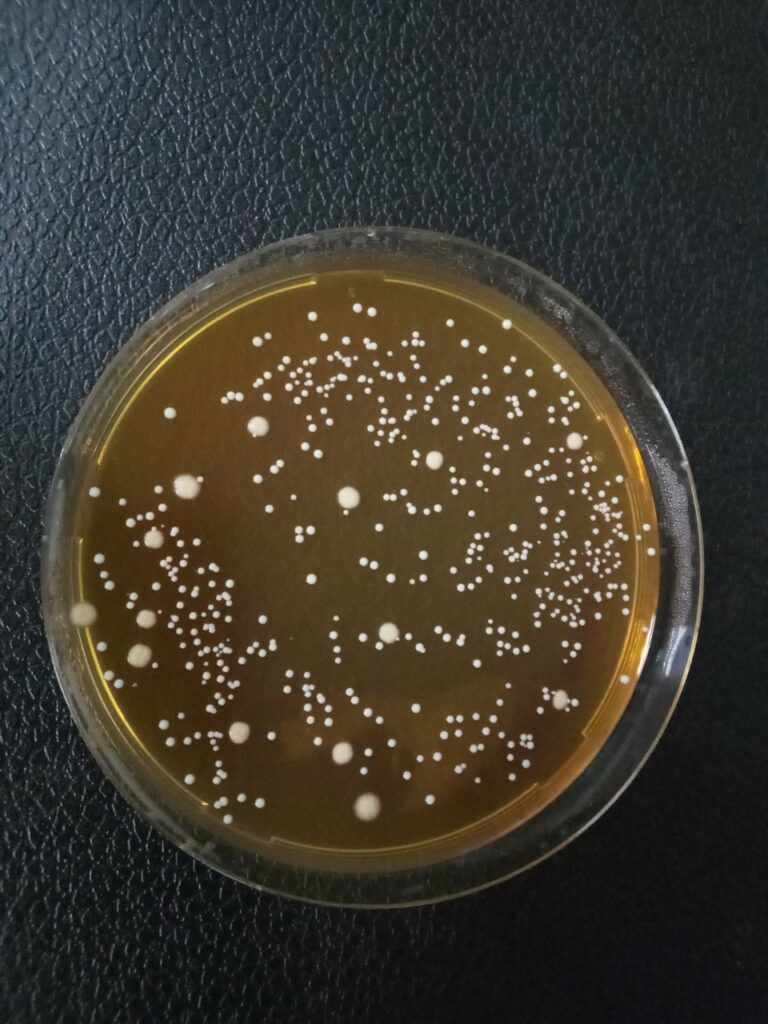

นักวิจัย ม.วลัยลักษณ์ พัฒนากล้าเชื้อผงปลาส้ม ช่วยผู้ประกอบการผลิตปลาส้มได้ทุกฤดูกาล

รองศาสตราจารย์ ดร.มณฑล เลิศคณาวนิชกุล นักวิจัยและอาจารย์ประจำสำนักวิชาสหเวชศาสตร์ ม.วลัยลักษณ์ เปิดเผยว่า ปลาส้มเป็นสินค้าหนึ่งตำบลหนึ่งผลิตภัณฑ์ (OTOP) ประเภทผลิตภัณฑ์อาหารหมัก ที่ประชาชนนิยมบริโภคในทุกภูมิภาคของประเทศไทย แต่ผู้ประกอบการผลิตภัณฑ์ปลาส้มยังใช้การหมักแบบพื้นบ้าน (Tradition Fermented) จึงมักพบปัญหาเรื่องการควบคุมคุณภาพของผลิตภัณฑ์ ซึ่งเกิดการปนเปื้อนของเชื้อจุลินทรีย์และสารเคมีที่อาจเกิดอันตรายต่อผู้บริโภค ตลอดจนระยะเวลาการหมักผลิตภัณฑ์ และรสชาติยังไม่คงที่ ส่งผลให้ผู้ประกอบการยังไม่สามารถขอการรับรองตามมาตรฐานผลิตภัณฑ์ชุมชนได้ ดังนั้นเพื่อหาแนวทางการรักษาคุณภาพของการผลิตปลาส้มให้คงที่สม่ำเสมอ
ทีมนักวิจัยของสำนักวิชาสหเวชศาสตร์ จึงได้ร่วมกันคิดค้นกล้าเชื้อผงสำหรับผลิตปลาส้มขึ้น ด้วยการใช้กล้าเชื้อผงของแบคทีเรียแลคติก แทนการคัดเลือกจุลินทรีย์จากธรรมชาติที่มีปะปนมากับวัตถุดิบที่นำมาใช้ในการผลิตปลาส้ม เพื่อทำให้เกิดปลาส้มที่มีคุณภาพคงที่ ลดระยะเวลาการผลิต ลดการปนเปื้อนของเชื้อโรค เกิดความน่าเชื่อถือต่อผู้บริโภคและเป็นที่ต้องการของตลาดมากยิ่งขึ้น ที่สำคัญคัญเพื่อให้สามารถยกระดับไปสู่ตลาดต่างประเทศได้ในอนาคต
รองศาสตราจารย์ ดร.มณฑล กล่าวถึงวิธีการผลิตผงกล้าเชื้อปลาส้มว่า เริ่มจากการเลี้ยงแบคทีเรียแลคติก ซึ่งแยกได้จากปลาส้ม คือ แลคโตบาซิลลัส ซาลิวาเรียส (Lactobacillus salivarius) หรือ ลิวโคนอสต็อค มีเซ็นเทอรอยเดส (Leuconostoc mesenterodies) ในอาหารเลี้ยงเชื้อเหลว ดีแมน-โรโกซ่า-ชาร์ป (de Mann-Rogosa-Sharpe) ที่อุณหภูมิ 35-37 องศาเซลเซียส เป็นระยะเวลา 4-6 วัน กระตุ้นให้เชื้อมีการเจริญเติบโตคงที่ และปั่นแยกเอาส่วนของตะกอนเชื้อมาใช้เตรียมเป็นกล้าเชื้อผงบนวัสดุยึดเกาะ 2 ชนิด คือ แป้งข้าวเจ้าและแป้งข้าวเหนียว และได้เป็นกล้าเชื้อผงปลาส้มออกมา
รองศาสตราจารย์ ดร.มณฑล กล่าวต่อไปอีกว่า กล้าเชื้อที่ผลิตออกมาสามารถผลิตได้หลายรูปแบบ ทั้งแบบผง ของเหลว หรือแบบเม็ด แต่ที่นิยมใช้เป็นกล้าเชื้อผง เนื่องจากสะดวกในการขนส่งและง่ายต่อการใช้งาน สามารถนำมาใช้เป็นกล้าเชื้อการหมักเพื่อควบคุมกระบวนการผลิต และคุณภาพของผลิตภัณฑ์ได้ ซึ่งกล้าเชื้อผงนอกเหนือจะนำไปใช้ผลิตปลาส้มแล้ว ยังสามารถนำไปประยุกต์ใช้เป็นหัวเชื้อตั้งต้นในกระบวนการหมักเพื่อถนอมอาหารชนิดอื่นได้ เช่น น้ำนมหมัก น้ำผลไม้โพรไบโอติก เป็นต้น ที่สำคัญยังช่วยผู้ประกอบการสามารถผลิตปลาส้มได้ตลอดทั้งปี สามารถยกระดับไปสู่ตลาดต่างประเทศต่อไป
“มหาวิทยาลัยวลัยลักษณ์ใช้องค์ความรู้ด้านวิทยาศาสตร์และเทคโนโลยีส่งเสริมผลิตสินค้าภายในประเทศ โดยมุ่งเน้นการพัฒนาและยกระดับคุณภาพการผลิต OTOP นำไปสู่การสร้างขีดความสามารถในการแข่งขันและขยายศักยภาพทางการค้า รวมถึงความปลอดภัยของผู้บริโภค ซึ่งการพัฒนาผลิตภัณฑ์กล้าเชื้อผงปลาส้ม นอกจากจะเป็นการช่วยเหลือผู้ประกอบการแล้ว ยังทำให้เกิดการบูรณาการการวิจัย การเรียนการสอน การบริการวิชาการ และยังใช้เป็นตัวอย่างให้กับนักศึกษาในการเรียนการสอน และได้ฝึกปฎิบัติจริงกับผู้ผลิตผลิตภัณฑ์ในชุมชนได้อีกช่องทางหนึ่งที่สำคัญคือสามารถพัฒนาให้เกิดกลุ่มนักวิจัยขึ้นได้ในชุมชนแบบยั่งยืน” รองศาสตราจารย์ ดร.มณฑล กล่าว

ข่าวโดยนายธีรพงศ์ หนูปลอด ส่วนสื่อสารองค์กร
ขอขอบคุณภาพและข้อมูลจากอุทยานวิทยาศาสตร์และเทคโนโลยี
